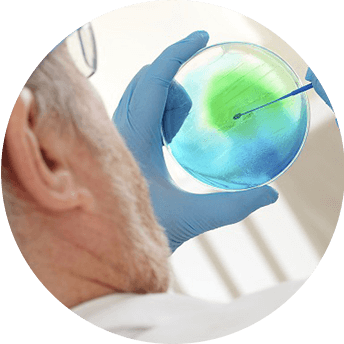

Scope of Standards:
ISO 10993-1: Part 1: Evaluation and testing.
ISO 10993-3: Part 3: Tests for genotoxicity, carcinogenicity and reproductive toxicity.
ISO 10993-4: Part 4: Selection of tests for interactions with blood.
ISO 10993-5: Part 5: Tests for in vitro cytotoxicity.
ISO 10993-6: Part 6: Tests for local effects after implantation.
ISO 10993-7: Part 7: Ethylene Oxide Sterilization Residual
ISO 10993-9: Part 9: Framework for identification and quantification of potential degradation products.
ISO 10993-10: Part 10: Tests for irritation and delayed-type hypersensitivity.
ISO 10993-11: Part 11: Tests for systemic toxicity.
ISO 10993-13: Part 13: Identification and quantification of degradation products from polymeric medical devices.
ISO 10993-14: Part 14: Identification and quantification of degradation products from ceramics.
ISO 10993-15: Part 15: Identification and quantification of degradation products from metals and alloys.
ISO 10993-16: Part 16: Toxicokinetic study design for degradation products and leachables.
ISO 10993-17: Part 17: Establishment of allowable limits for leachable substances.
ISO 10993-18: Part 18: Chemical characterization of materials.
ISO/TS 10993-19: Part 19: Physico-chemical, morphological and topographical characterization of materials.
ISO/TS 10993-20: Part 20: Principles and methods for immunotoxicology testing of medical devices.